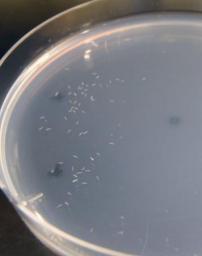
九州大、線虫を用いて尿1滴からがんを検出する技術を開発

Politics Readings

県の停止指示「無効」 農相意向防衛局作業続行へ 辺野古移設
米軍普天間飛行場(沖縄県宜野湾市)の名護市辺野古移設をめぐり、林芳正農相は28日、翁長雄志(おながたけし)知事が沖縄防衛局に出した作業停止の指示を一時的に無効とする意向を固めた。30日にも発表する。これにより防衛局は辺野古沿岸部の海底ボーリング調査を ...佐賀新聞 ·
花粉症薬、危険で医師も飲まない?脳出血、不整脈、内蔵機能抑制、感染症の恐れ
花粉症患者数は増加の一途をたどり、スギ花粉症だけで1500万人以上、日本の花粉症総人口は2000万人以上、5人に1人は花粉症ともいわれ、今後も増加することが予想されています。 実はこの花粉症、古代エジプトの文献にも登場するため、まったく新しい病気というわけ ...
統一地方選:5政令市長選も告示 17人届け出
第18回統一地方選の5政令市長選が29日告示され、計17人が立候補を届け出た。26日に告示された10道県知事選、4月3日告示の41道府県議選、17政令市議選とともに4月12日に投開票される。 告示されたのは札幌市、相模原市、広島市、静岡市、浜松市の5市。現職4 ...毎日新聞 ·![[「わが軍」発言] 撤回したらどうですか](/assets/images/reading/318064.jpg)
[「わが軍」発言] 撤回したらどうですか
だが、それが首相の国会答弁であり、しかも憲法をないがしろにする内容なら話は別である。 安倍晋三首相が参院予算委員会で自衛隊を「わが軍」と呼んだ。耳を疑う発言であり、野党が反発するのは当然だ。 その後の記者会見で、菅義偉官房長官は条件付きながら「自衛隊も ...南日本新聞 ·
夏の霞が関、登庁早め「朝型」に 残業抑制へ政府方針
今年の夏は日が暮れないうちに家路へ――。政府は27日、国家公務員の長時間労働の抑制をめざし、7~8月の2カ月間の勤務時間帯を見直す実施方針をまとめた。出勤時間を1~2時間程度早める代わりに帰宅時間も早めるなど、霞が関を「朝型シフト」にする取り組みだ。朝日新聞 ·
政府、邦人救出で5事例を提示 安保法制巡り公明に
政府は11日、新たな安全保障法制をめぐり、海外でテロなどに巻き込まれた邦人を自衛隊が武器を使用して救出するケースとして「邦人の集合場所が暴徒らに取り囲まれた場合」など5事例を公明党に示した。政府は具体的な事例と派遣の条件を示すことで、歯止めを求める ...朝日新聞 ·
選挙:県議選 立候補説明会に70陣営−−県庁 /熊本
統一地方選第1ラウンドの県議選(4月3日告示、12日投開票)の立候補予定者説明会が11日、県庁であり、70陣営が出席した。 県議選の定数は前回から1減の48。現時点では▽人吉市(定数1)▽荒尾市(同2)▽山鹿市(同2)▽合志市(同1)▽玉名郡(同1)▽芦北郡( ...毎日新聞 ·
在日米軍再編:普天間移設 辺野古掘削再開 海上で怒号、もみ合い 「いつまで沖縄犠牲」
沖縄県知事、名護市長、そして県民の多数が反対する中、防衛省は12日、米軍普天間飛行場(沖縄県宜野湾市)の名護市辺野古への県内移設に向けた海底ボーリング調査を再開した。現場海域では小型船で抗議する反対派と警備する海上保安官が一時もみ合いになり、怒号 ...毎日新聞 ·
官房長官「自分でも談話出したのに」 小泉元首相に反論
菅義偉官房長官は12日午前の記者会見で、戦後70年に合わせて出す安倍談話について小泉純一郎元首相が「別に10年ごとに出す必要もない」と述べたことに対し、「ご自身でも談話を出しておいて、なぜそういうことを言うのか」と反論した。 小泉氏は2005年に小泉談話を ...朝日新聞 ·
九州大、線虫を用いて尿1滴からがんを検出する技術を開発
九州大学(九州大)は3月12日、線虫は尿によって高精度にがんの有無を識別することができると発表した。実用化されれば、尿1滴でさまざまな早期がんを数百円で高精度に検出できるようになる。 同成果は九州大学大学院理学研究院/味覚・嗅覚センサ研究開発センターの広津 ...マイナビニュース ·
政府、IS邦人人質事件検証委の有識者メンバー発表
過激派組織「イスラム国」(IS)による邦人人質事件をめぐり、菅義偉官房長官は12日午前の記者会見で、政府の危機対応を検証する委員会で意見を聴く有識者として池内恵(さとし)・東大先端科学技術研究センター准教授ら5人を選んだと発表した。 「イスラム国」人質事件.朝日新聞 ·
政治とカネ:内閣支持率が下落傾向 自民に危機感じわり
内閣支持率が下落傾向を示し始め、自民党内にじわじわと危機感が広がりつつある。党幹部らは閣僚の「政治とカネ」を巡る問題が長期化したためとみて、統一地方選を前に引き締めに動き出した。 関連記事. 日銀追加緩和なら経済は「オーバーヒート」=本田内閣官房参与[WSJ ...毎日新聞 ·
反都構想団体が決起集会、大阪 大規模集会やデモ実施へ
大阪市を廃止し特別区に分割する「大阪都構想」や橋下徹市長の政治手法に反対する首長や議員などが賛同して発足した団体「民意の声」が10日、市内で決起集会を開いた。 4月の統一地方選や5月17日に実施される見通しの都構想の住民投票を前に、大規模な集会やデモ ...47NEWS ·
携帯での安否確認、海外旅行者も テロ対策で外務省
外務省は邦人人質事件を受けた安全強化策として、来週にも運用を始める携帯電話のショートメッセージによる安否確認システムについて、旅行や出張の短期渡航者にも対象を広げる方針を固めた。留学生を送り出す学校や、出張者を派遣する企業側も現地の治安情報を共有 ...信濃毎日新聞 ·
安倍首相:4月下旬からの訪米表明 与党党首会談
安倍晋三首相は10日、公明党の山口那津男代表と首相官邸で会談し、安全保障法制について与党協議の進展を見守ることで一致した。また、首相は会談で「訪米を考えている」と述べ、4月下旬からの大型連休中に訪米し、オバマ米大統領と会談する意向を表明した。 安保法制 ...毎日新聞 ·